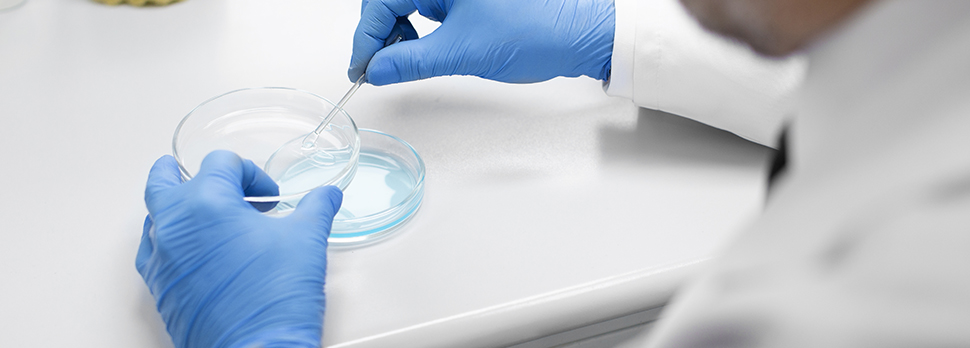

Na reprodução assistida, cada etapa — da coleta ao cultivo embrionário — depende de máxima precisão e controle. Por isso, a escolha dos materiais utilizados em laboratório não pode ser aleatória. A validação de fornecedores de descartáveis é uma prática fundamental para assegurar segurança, consistência e previsibilidade nos resultados.
Homologar um fornecedor envolve muito mais do que comparar preços. Exige análise técnica, avaliação documental, verificação regulatória e um histórico sólido de qualidade. Este artigo apresenta critérios essenciais para validar parceiros com segurança, orientando clínicas e laboratórios a construir processos confiáveis e alinhados às melhores práticas do setor.
Por que a validação de fornecedores é essencial na reprodução humana?

A embriologia e a reprodução assistida trabalham com gametas e embriões extremamente sensíveis. Um único consumível de baixa qualidade pode provocar:
- contaminação química ou biológica,
- alterações no pH ou osmolaridade,
- perda de viabilidade embrionária,
- resultados inconsistentes,
- falhas durante auditorias e inspeções.
A validação é, portanto, uma etapa estratégica de controle de qualidade na reprodução assistida, garantindo que cada item utilizado seja seguro, rastreável e adequado para uso clínico.
Critérios essenciais para validar fornecedores de descartáveis

1. Conformidade regulatória
O primeiro passo é garantir que o fornecedor opere dentro das normas nacionais. Isso inclui:
- registro ativo e regularizado na Anvisa;
- produtos com certificação e documentação compatível;
- histórico sem pendências sanitárias ou notificações graves.
Essa avaliação impede que itens sem respaldo regulatório entrem em contato com material biológico sensível.
2. Qualidade documental
Um bom fornecedor deve disponibilizar documentação clara e completa, como:
- Certificados de Análise (CoA);
- laudos de lote;
- fichas técnicas detalhadas;
- instruções de uso;
- evidências de boas práticas de fabricação.
Documentação bem estruturada facilita rastreabilidade e auditorias.
3. Reputação e histórico de mercado
Ao qualificar fornecedores na área da saúde, é fundamental verificar:
- tempo de atuação no segmento;
- estabilidade na produção e nos lotes;
- feedback de outras clínicas e laboratórios;
- histórico de não conformidades e como foram resolvidas.
Fornecedores consistentes entregam segurança operacional e menor risco.
Avaliação técnica dos consumíveis

1. Consistência lote a lote
Antes de homologar definitivamente um fornecedor, é importante testar a homogeneidade dos lotes:
- estabilidade física,
- ausência de deformações,
- comportamento previsível nas rotinas laboratoriais.
Essa etapa garante que não haverá surpresas no uso clínico.
2. Rastreabilidade completa
A rastreabilidade de lote e validade precisa estar visível e padronizada:
- número de lote legível;
- data de fabricação e validade;
- código único quando disponível.
3. Compatibilidade com a rotina da embriologia
Consumíveis devem se integrar sem problemas à rotina do laboratório:
- compatibilidade com incubadoras e sistemas de aquecimento;
- desempenho adequado com pipetas e equipamentos;
- estabilidade química e térmica durante o uso.
Esses testes práticos evitam retrabalhos e garantem segurança.
Como realizar a homologação de fornecedores na prática

A seguir, um passo a passo objetivo para validar fornecedores de descartáveis na reprodução assistida:
- Coleta de documentação – solicite registros, CoA, fichas técnicas e certificações;
- Avaliação regulatória – confirme regularidade na Anvisa;
- Teste técnico interno – valide o lote inicial em pequena escala;
- Auditoria remota ou presencial – verifique processos e padrões de qualidade;
- Checklist padronizado – avalie critérios técnicos, logísticos e regulatórios;
- Aprovação condicional – utilize o fornecedor de forma limitada até comprovar consistência;
- Homologação final – formalize após garantir estabilidade e segurança;
- Reavaliação periódica – audite anualmente ou conforme indicadores internos.
Esse processo cria segurança técnica e respaldo documental para auditorias.
Indicadores de desempenho para monitorar fornecedores

Mesmo após homologado, o fornecedor deve ser acompanhado regularmente. Indicadores importantes incluem:
- taxa de não conformidades por lote;
- frequência de devoluções ou trocas;
- pontualidade nas entregas;
- variação entre lotes;
- suporte técnico disponível;
- impacto percebido na rotina laboratorial.
Como a Ingámed apoia a validação e qualificação de fornecedores
A Ingámed facilita o processo de validação oferecendo:
- documentação completa: lote, validade, certificados e instruções;
- consistência lote a lote, garantindo reprodutibilidade;
- embalagens claras e organizadas, que simplificam auditorias;
- produtos desenvolvidos sob padrões rigorosos de qualidade.
Isso permite que clínicas e laboratórios mantenham controle rígido, cumpram boas práticas e fortaleçam a segurança operacional.
Conclusão
A validação de fornecedores é uma etapa crucial para garantir segurança, previsibilidade e confiabilidade nos ciclos de reprodução assistida. Seguir critérios técnicos, regulatórios e documentais reduz riscos e assegura a qualidade dos materiais utilizados diariamente.
Laboratórios que adotam processos sólidos de homologação protegem seus pacientes, sua equipe e seus resultados. E ao contar com fornecedores comprometidos com transparência, rastreabilidade e controle de qualidade — como a Ingámed — o processo se torna mais seguro, claro e eficiente.